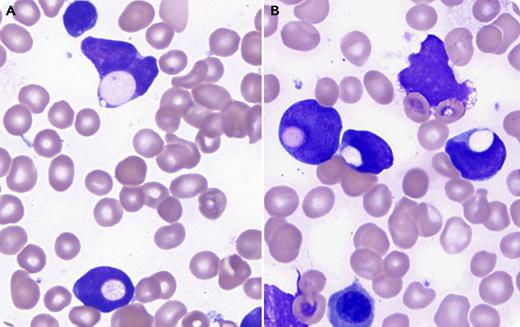
A 14-year-old, previously healthy adolescent girl presented with fatigue, shortness of breath, and headache for 1 month. Laboratory tests showed pancytopenia (hemoglobin, 4.7 g/dL; platelet count, 57 × 109/L; neutrophil count, 1.2 × 109/L) and 21% blasts. Bone marrow aspirate revealed 90% small- to medium-sized L1 lymphoblasts with frequent (22%) erythrophagocytosis (panels A-B: Wright’s stain, original magnification ×1000). Flow cytometry study was suggestive of pro‐B-cell acute lymphoblastic leukemia (B-ALL; CD19+TdT+CD10−) with aberrant partial expression of CD13 and CD33. Cytogenetic study showed a near-tetraploidy karyotype of 87<4n>, XX,-X,-X, add(1)(p36.1)x2,-7,-8, add(12)(p11.2), add(12)(p12), -14, -15, add(15)(q15), der(20) t(5;20) (q12;p11.2), +add(22)(p11.2), add(22)(q12). FISH analysis confirmed near-tetraploidy and ETV6/RUNX1 gene rearrangement. The diagnosis of precursor B-ALL was made. This patient was treated on a high-risk protocol because of age (>10 years) and achieved complete remission. She has been disease free for ≥5 years. / Erythrophagocytosis by leukemic blasts is a rare phenomenon of unknown pathogenesis and unclear clinical significance. It is mostly seen in acute myeloid leukemia, especially associated with monocytic differentiation, t(8;16)(p11;p13), t(16;21)(p11;q22), inv8(p11q13), or tetraploidy, and poor prognosis. It is extremely rare in ALL, with only a few reported cases, 1 of which was pediatric B-ALL with ETV6/RUNX1 gene rearrangement and good prognosis.

A 14-year-old, previously healthy adolescent girl presented with fatigue, shortness of breath, and headache for 1 month. Laboratory tests showed pancytopenia (hemoglobin, 4.7 g/dL; platelet count, 57 × 109/L; neutrophil count, 1.2 × 109/L) and 21% blasts. Bone marrow aspirate revealed 90% small- to medium-sized L1 lymphoblasts with frequent (22%) erythrophagocytosis (panels A-B: Wright’s stain, original magnification ×1000). Flow cytometry study was suggestive of pro‐B-cell acute lymphoblastic leukemia (B-ALL; CD19+TdT+CD10−) with aberrant partial expression of CD13 and CD33. Cytogenetic study showed a near-tetraploidy karyotype of 87<4n>, XX,-X,-X, add(1)(p36.1)x2,-7,-8, add(12)(p11.2), add(12)(p12), -14, -15, add(15)(q15), der(20) t(5;20) (q12;p11.2), +add(22)(p11.2), add(22)(q12). FISH analysis confirmed near-tetraploidy and ETV6/RUNX1 gene rearrangement. The diagnosis of precursor B-ALL was made. This patient was treated on a high-risk protocol because of age (>10 years) and achieved complete remission. She has been disease free for ≥5 years.
Erythrophagocytosis by leukemic blasts is a rare phenomenon of unknown pathogenesis and unclear clinical significance. It is mostly seen in acute myeloid leukemia, especially associated with monocytic differentiation, t(8;16)(p11;p13), t(16;21)(p11;q22), inv8(p11q13), or tetraploidy, and poor prognosis. It is extremely rare in ALL, with only a few reported cases, 1 of which was pediatric B-ALL with ETV6/RUNX1 gene rearrangement and good prognosis.
A 14-year-old, previously healthy adolescent girl presented with fatigue, shortness of breath, and headache for 1 month. Laboratory tests showed pancytopenia (hemoglobin, 4.7 g/dL; platelet count, 57 × 109/L; neutrophil count, 1.2 × 109/L) and 21% blasts. Bone marrow aspirate revealed 90% small- to medium-sized L1 lymphoblasts with frequent (22%) erythrophagocytosis (panels A-B: Wright’s stain, original magnification ×1000). Flow cytometry study was suggestive of pro‐B-cell acute lymphoblastic leukemia (B-ALL; CD19+TdT+CD10−) with aberrant partial expression of CD13 and CD33. Cytogenetic study showed a near-tetraploidy karyotype of 87<4n>, XX,-X,-X, add(1)(p36.1)x2,-7,-8, add(12)(p11.2), add(12)(p12), -14, -15, add(15)(q15), der(20) t(5;20) (q12;p11.2), +add(22)(p11.2), add(22)(q12). FISH analysis confirmed near-tetraploidy and ETV6/RUNX1 gene rearrangement. The diagnosis of precursor B-ALL was made. This patient was treated on a high-risk protocol because of age (>10 years) and achieved complete remission. She has been disease free for ≥5 years.
Erythrophagocytosis by leukemic blasts is a rare phenomenon of unknown pathogenesis and unclear clinical significance. It is mostly seen in acute myeloid leukemia, especially associated with monocytic differentiation, t(8;16)(p11;p13), t(16;21)(p11;q22), inv8(p11q13), or tetraploidy, and poor prognosis. It is extremely rare in ALL, with only a few reported cases, 1 of which was pediatric B-ALL with ETV6/RUNX1 gene rearrangement and good prognosis.
For additional images, visit the ASH Image Bank, a reference and teaching tool that is continually updated with new atlas and case study images. For more information, visit http://imagebank.hematology.org.